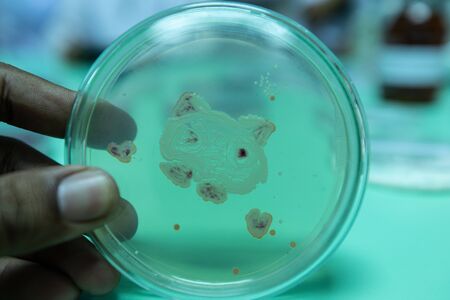
Backgrounds of Colony Characteristics of Bacteria in petri dish for education.の写真素材

写真素材 - Backgrounds of Colony Characteristics of Bacteria in petri dish for education.
作品情報
Backgrounds of Colony Characteristics of Bacteria in petri dish for education.
- ID:136089820
- 作品種別:写真
- 作者名:sinhyu
キーワード
- actinomyces
- agar
- analysis
- bacteria
- bacterial
- bacterium
- beautiful
- biology
- biotechnology
- colonies
- colony
- color
- culture
- danger
- disease
- dish
- education
- experiment
- germs
- growing
- growth
- health
- hygiene
- isolated
- lab
- laboratory
- medical
- medicine
- medium
- micro
- microbial
- microbiology
- microorganisms
- mix
- organism
- pathogen
- petri
- plate
- research
- safety
- sample
- science
- soil samples
- species
- staphylococcus
- streptococcus
- test
- white
- yeast
類似作品
Close-up of bac...
Macro close up ...
Surface contami...
Blue bacteria w...
Dynamic motion ...
Colorful bacter...
Bacteria macro ...
High-res image ...
3D microscope c...
Bacteria on a s...
Green bacteria ...
Close up view r...
Bacteria and vi...
A close up of a...
Conceptual imag...
Microscopic Vie...
Helicobacter py...
Microscopic per...
Pills encircle ...
High-res image ...
Bacteria of dif...
close-up of bac...
Proliferating b...
Multiple bacter...
High-definition...
High-resolution...
Bacteria on a s...
Enterobacterias...
Germs on a clea...
Vibrant depicti...
Digital illustr...
Close-up of ger...
3d illustration...
Microscopic fun...
Bilophila wadsw...
Bacteria, micro...
Close-up of mic...
Red bacteria on...
High-definition...
Digital germs m...
Petri dish with...
Surface with ba...
Colorful microo...
Unveil the hidd...
Bacteria on a c...
High-definition...
Close-up of pat...